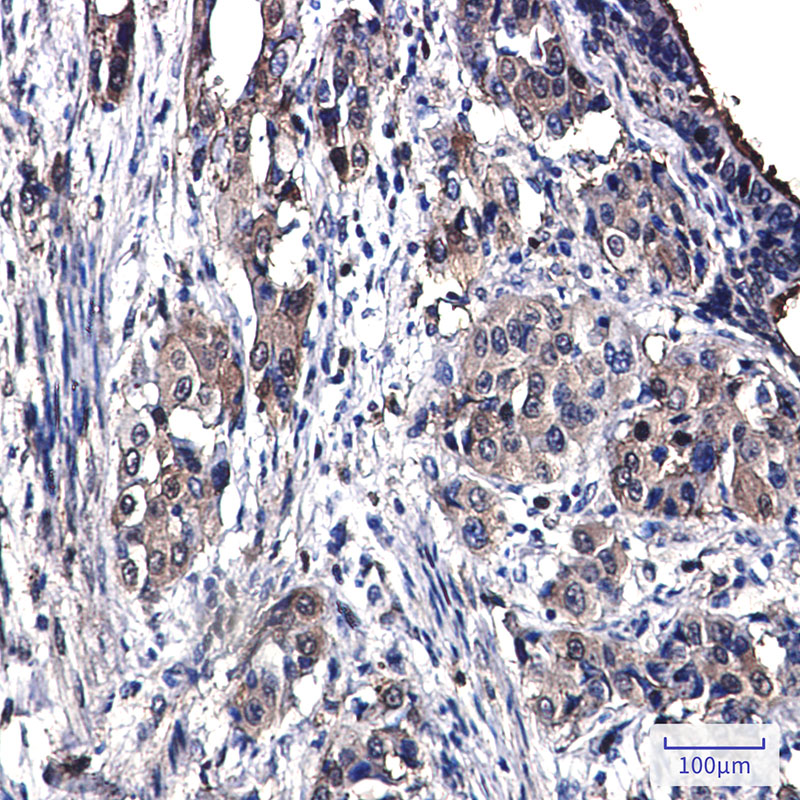

-
分类: 科研抗体货号: P22240别名: ACADM; Medium-chain specific acyl-CoA dehydrogenase; mitochondrial; MCAD应用: WB,IP,IHC,IF反应种属: Human,Mouse,Rat
-
分类: 科研抗体货号: P22220别名: EFTS; EFTSMT应用: WB反应种属: Human
-
分类: 科研抗体货号: P22238别名: 5T4; 5T4AG; M6P1; TPBG; 5T4 oncofetal antigen; Trophoblast glycoprotein应用: WB,IP反应种属: Human,Mouse,Rat
-
分类: 科研抗体货号: P22255别名: AIV; AnnexinA4; AnnexinIV; ANX 4; ANX A4; ANX4; ANXA4; Chromobindin4; EndonexinI; LipocortinIV; P32.5; P33/41; PAPII; PIG28; PP4X; Protein II; Xanx-4; ZAP36应用: WB,IHC,IF反应种属: Human,Mouse,Rat,Hamster
-
分类: 科研抗体货号: P22219别名: C2orf38应用: WB反应种属: Human
-
分类: 科研抗体货号: P22217别名: YVS; BTOP; SAC3; ALS11; CMT4J; KIAA0274; dJ249I4.1应用: WB,IP反应种属: Human
-
分类: 科研抗体货号: P22254别名: ANXA2; ANX2; ANX2L4; CAL1H; LPC2D; Annexin A2; Annexin II; Annexin-2; Calpactin I heavy chain; Calpactin-1 heavy chain; Chromobindin-8; Lipocortin II; Placental anticoagulant protein IV; PAP-IV; Protein I; p36应用: WB,IP反应种属: Human
-
分类: 科研抗体货号: P22253别名: AMSH; MICCAP应用: WB反应种属: Human
-
分类: 科研抗体货号: P22237别名: YWHAG; 14-3-3 protein gamma; Protein kinase C inhibitor protein 1; KCIP-1应用: WB反应种属: Human,Mouse,Rat
-
分类: 科研抗体货号: P22251别名: INA; NEF5; Alpha-internexin; Alpha-Inx; 66 kDa neurofilament protein; NF-66; Neurofilament-66; Neurofilament 5应用: WB,IP,IHC,IF反应种属: Human,Mouse,Rat

鄂公网安备42018502007531号
鄂公网安备42018502007531号

